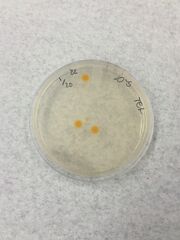

Uploads by Zoe Love
From OpenWetWare
Jump to navigationJump to search
This special page shows all uploaded files.
| Date | Name | Thumbnail | Size | Description |
|---|---|---|---|---|
| 17:37, 17 February 2016 | ZoeLoveFoodWeb.png (file) |  |
737 KB | |
| 16:12, 17 February 2016 | ZoeLoveTermite.jpg (file) |  |
1.09 MB | |
| 16:11, 17 February 2016 | ZoeLoveLiceClose.jpg (file) |  |
129 KB | |
| 16:10, 17 February 2016 | ZoeLoveLice.jpg (file) |  |
1.31 MB | |
| 16:09, 17 February 2016 | ZoeLoveFly.jpg (file) |  |
1.24 MB | |
| 16:06, 17 February 2016 | ZoeLoveBugTable.png (file) |  |
88 KB | |
| 21:08, 12 February 2016 | ZoeLoveDeadLeaf.jpg (file) |  |
1.11 MB | |
| 21:07, 12 February 2016 | ZoeLoveCloverCross.jpg (file) |  |
1.19 MB | |
| 21:06, 12 February 2016 | ZoeLoveGrassCrossSection.jpg (file) |  |
989 KB | |
| 21:04, 12 February 2016 | ZoeLovePlantTable.png (file) |  |
101 KB | |
| 20:39, 12 February 2016 | ZoeLoveClover.jpg (file) |  |
1.33 MB | |
| 20:38, 12 February 2016 | ZoeLoveGrass.jpg (file) |  |
1.53 MB | |
| 20:37, 12 February 2016 | ZoeLoveleaf.jpg (file) |  |
1.55 MB | |
| 20:37, 12 February 2016 | ZoeLovebrownleaf.jpg (file) |  |
1.22 MB | |
| 18:18, 10 February 2016 | ZoeLoveBacilli.JPG (file) |  |
1.35 MB | |
| 18:16, 10 February 2016 | ZoeLovetetBacilli.jpg (file) |  |
1.77 MB | |
| 03:11, 10 February 2016 | ZoeLoveTable2Better.png (file) |  |
69 KB | |
| 03:09, 10 February 2016 | ZoeLovecocci.jpg (file) |  |
1.33 MB | 10^-3 |
| 03:07, 10 February 2016 | ZoeLoveTable2.png (file) |  |
69 KB | |
| 02:45, 10 February 2016 | ZoeLovetet105.jpg (file) | |
1.26 MB | |
| 02:44, 10 February 2016 | ZoeLovetet103.jpg (file) |  |
1.22 MB | |
| 02:37, 10 February 2016 | ZoeLovetable1.png (file) |  |
79 KB | |
| 02:36, 10 February 2016 | ZoeLoveTable 1.png (file) |  |
81 KB | Table 1 |
| 19:20, 3 February 2016 | Niche2.JPG (file) |  |
691 KB | Niche 2 organism |
| 19:16, 3 February 2016 | Lab2.1.JPG (file) |  |
755 KB | Drawing of protist from Niche 1. |
| 16:37, 27 January 2016 | LabNotebookImage1.jpg (file) |  |
791 KB | Work that I did in my Lab notebook including a drawing of the transect |
| 19:44, 25 January 2016 | Transect1Photo.jpg (file) |  |
3.8 MB | |
| 19:15, 20 January 2016 | Image-IMG 0742.jpg (file) |  |
791 KB | |
| 03:14, 20 January 2016 | IMG 0742.jpg (file) |  |
791 KB | Drawing of transect number one from bird's eye view. Includes description of transect and abiotic and biotic life. |
| 03:12, 20 January 2016 | IMG 0689.jpg (file) |  |
3.8 MB | Photo of Transect number 1 facing north-east. |